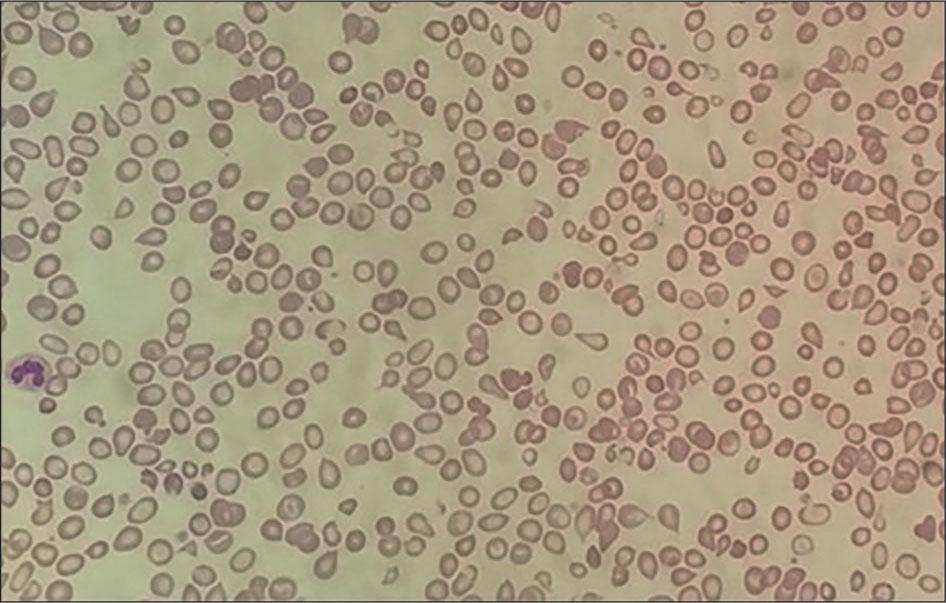

Figure 1.

© 2024 R Bahar, Z Zulkafli, RH Zulkeflee, MN Hassan, S Wan Ab Rahman Wan, NH M Noor, M Ramli, A Hussin, AD Abdullah, S Iberahim, M Abdullah, S M Yusoff, published by Macedonian Academy of Sciences and Arts
This work is licensed under the Creative Commons Attribution-NonCommercial-NoDerivatives 3.0 License.